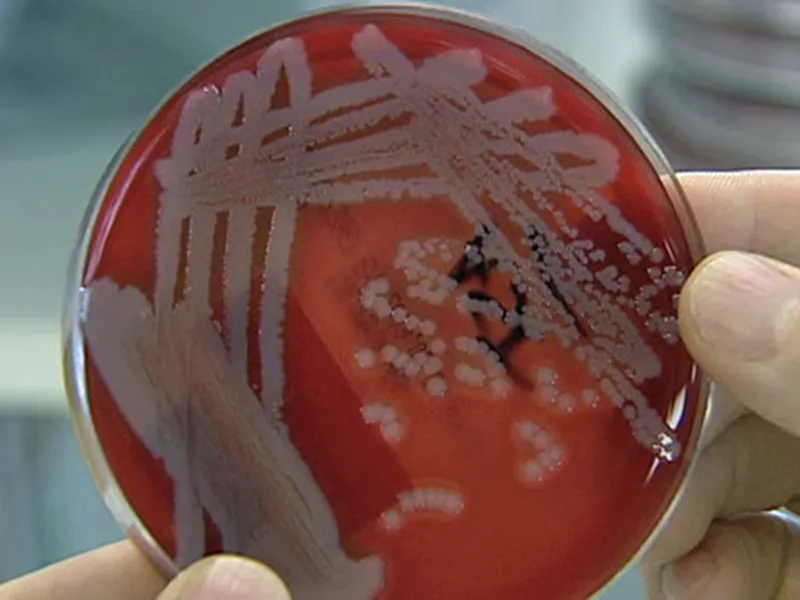

Far North Queensland reports two deaths, 28 cases of bacterial disease melioidosis in 2025: ABC
LATEST
-

Plants, People, Planet – AIH conference PLUS Awards Dinner, AGM and Horticultural Tour
-

Experiment uses atmospheric plasma – a technology already used in medicine and agriculture – to extend the life of cut flowers.
-

Avocado – Bruising While Choosin – YouTube
-

Soils Workshop, Pine Crest Orchard, Bilpin
